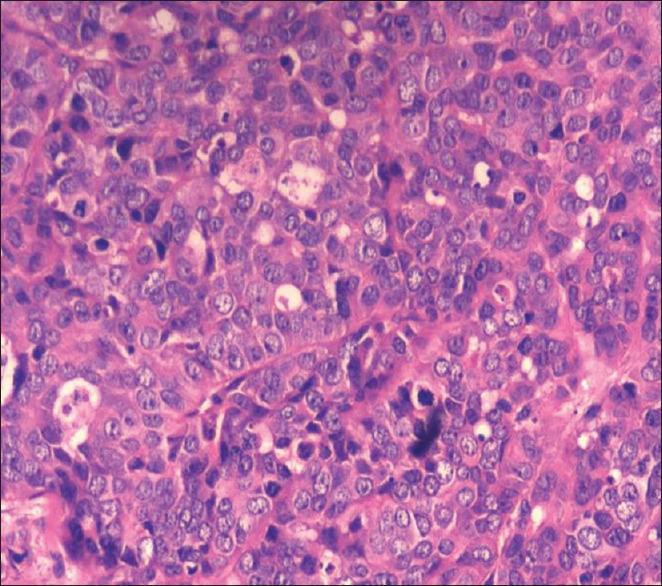
https://cdn.ncbi.nlm.nih.gov/pmc/blobs/73e9/7640794/495fb99c6b49/IJD-65-420-g003.jpg

原发性子宫内膜癌伴带状疱疹样皮肤转移
Zosteriform Cutaneous Metastases with Primary Endometrial Carcinoma.
作者信息
Raghupathy Roopa, Priyadarshini Anuradha, Mahalakshmi V, Sudha R, Krishnakanth M, Priya M Banu
机构信息
Department of Dermatology and Venereology, Sri Ramachandra Medical College and University, Chennai, Tamil Nadu, India.
出版信息
Indian J Dermatol. 2020 Sep-Oct;65(5):420-422. doi: 10.4103/ijd.IJD_339_18.
Cutaneous metastases from endometrial adenocarcinoma are ominous and are seldom seen, though metastases occurring at the local sites, such as pelvic and para-aortic lymph nodes, vagina, peritoneum, and lungs are well recognized. The zosteriform pattern of lesions is even more rare. Here, we describe an interesting case of a 60-year-old female with carcinoma endometrium, presenting with zosteriform cutaneous metastasis.
子宫内膜腺癌的皮肤转移预后不佳且很少见,尽管发生在局部部位的转移,如盆腔和腹主动脉旁淋巴结、阴道、腹膜和肺部的转移已广为人知。带状疱疹样皮损模式更为罕见。在此,我们描述一例有趣的病例,一名60岁患有子宫内膜癌的女性出现带状疱疹样皮肤转移。